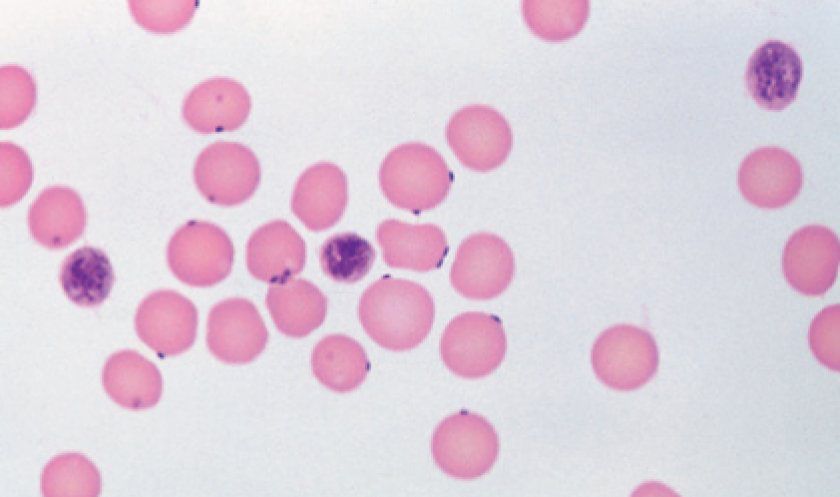
Mycoplasme

Mycoplasmose chez le chat : symptômes et traitement
La mycoplasmose chez le chat est une maladie assez grave et très contagieuse qui affecte les systèmes respiratoire, musculo-squelettique et génito-urinaire. Il est important que les propriétaires d'animaux connaissent les symptômes de cette maladie et les mesures à prendre pour un traitement rapide.

Contenu
L’agent causal de la maladie et les voies d’infection
Les mycoplasmes sont des procaryotes unicellulaires Gram négatif dépourvus de paroi cellulaire et d'organites internes. Leur température optimale de croissance se situe entre 37 et 38 °C ; ils sont relativement résistants aux basses températures. Cependant, à des températures supérieures à 60 °C, ainsi que sous l'effet des ultrasons et de la lumière directe du soleil, ces bactéries meurent en moins de 10 minutes. Les mycoplasmes présentent une résistance à de nombreux antibiotiques, mais sont très sensibles aux désinfectants.
Il existe de nombreuses espèces de ces procaryotes, et les chats sont affectés par deux d'entre elles : Mycoplasma felis et Mycoplasma gatae. Les mycoplasmes sont des pathogènes opportunistes : un chat peut être porteur de l'infection sans nécessairement développer la maladie. La mycoplasmose se transmet par contact, notamment sexuel, par voie aérienne (gouttelettes), par voie transplacentaire (intra-utérine) et de la mère à la mère lors du passage des chatons dans le canal utérin. Les chats à risque sont ceux de moins de 2 ans, les chats âgés et ceux souffrant de maladies chroniques ou dont le système immunitaire est affaibli.
Symptômes de la mycoplasmose
Les premiers signes de mycoplasmose chez le chat apparaissent 3 à 5 jours après l'infection. Au cours de leur cycle de vie, les bactéries Mycoplasma produisent de grandes quantités de toxines qui endommagent les cellules de divers organes ; les symptômes de la mycoplasmose sont donc similaires à ceux d'autres maladies infectieuses.

Les manifestations cliniques comprennent :
- conjonctivite séreuse (inflammation et rougeur des muqueuses des yeux) ;
- éternuements, toux ;
- perte d'appétit ;
- perte de poids ;
- augmentation de la température ;
- mictions fréquentes ;
- faiblesse, apathie.
Dans les cas bénins de la maladie et en l'absence de pathologies concomitantes, la guérison survient en 1 à 1,5 semaine.
En cas d'infection généralisée ou de faible résistance de l'organisme, des symptômes plus dangereux apparaissent :
- cutané ou abcès sous-cutanés (inflammation purulente des tissus) ;
- gonflement des paupières, écoulement purulent des yeux ;
- troubles urinaires (augmentation de la fréquence ou retard) ;
- inflammation et hypertrophie des ganglions lymphatiques ;
- Le système génito-urinaire de l'animal est affecté (une cystite se développe, néphrite ou prostatite);
- une polyarthrite (inflammation des articulations) se développe, caractérisée par une boiterie et un gonflement des membres ; le chat ressent de la douleur lorsqu’on le prend dans les bras ou lorsqu’on lui touche les pattes ;
- Les chattes gestantes atteintes de formes graves de la maladie subissent souvent des fausses couches ou donnent naissance à des chatons mort-nés.
Si vous remarquez au moins plusieurs des symptômes de mycoplasmose énumérés chez votre chat, vous devriez le montrer à un vétérinaire.
Diagnostic de la mycoplasmose
Pour établir un diagnostic, le vétérinaire examine le chat et pose au propriétaire des questions détaillées sur les symptômes détectés chez l'animal, le moment de leur apparition, la présence de maladies chroniques, le mode de vie et l'âge de l'animal.

Le chat subira ensuite une série d'examens de laboratoire et d'imagerie afin de différencier la mycoplasmose d'autres maladies présentant des symptômes similaires. Ces examens peuvent comprendre :
- Analyses sanguines cliniques et biochimiques (en cas d'inflammation, elles montreront une augmentation du nombre de leucocytes et une augmentation de la VS, une diminution du taux d'hémoglobine et d'érythrocytes).
- Les tests se font par prélèvement (des écouvillons peuvent être prélevés sur les muqueuses des yeux, du nez, de la bouche ou des organes génitaux ; des échantillons de sang peuvent également être utilisés pour une analyse générale). L’analyse est réalisée par PCR (qui détecte de faibles concentrations de fragments d’ADN pathogène dans le matériel biologique) ou par ELISA (qui repose sur la réaction antigène-anticorps et permet de détecter les virus et les bactéries dans l’échantillon).
- Analyse d'urine pour déterminer la sensibilité du pathogène aux antibiotiques.
Traitement de la mycoplasmose
La mycoplasmose chez le chat, sauf en cas de complications graves, ne nécessite pas d'hospitalisation et se traite en ambulatoire. Le traitement dure généralement au moins trois semaines. Il comprend un traitement primaire, visant à éradiquer l'agent pathogène, et un traitement symptomatique, visant à soulager les manifestations externes de la maladie et à renforcer le système immunitaire.

Pour choisir un traitement contre la mycoplasmose chez le chat, le vétérinaire se base sur les manifestations cliniques de la maladie et les résultats des tests permettant de déterminer le degré de résistance aux antibiotiques de la souche de mycoplasme détectée.
Les mycoplasmes présentent une résistance relativement élevée à de nombreux médicaments. Par exemple, les sulfamides et certains types d'antimicrobiens (antibiotiques) sont inefficaces contre eux.
Parmi les agents antimicrobiens, les procaryotes sont les plus sensibles aux antibiotiques du groupe des tétracyclines :
- Doxycycline ;
- Éravacycline ;
- Minocycline;
- Omadacycline ;
- Tétracycline.
Ils inhibent les processus de synthèse et provoquent la mort des mycoplasmes :
- composés du furane (pyrrole, furane, thiophène) ;
- fluoroquinolones (ciprofloxacine, norfloxacine, lévofloxacine, gémifloxacine, moxifloxacine) ;
- macrolides (clarithromycine, roxithromycine, dirithromycine) ;
- aminoglycosides (amikacine, néomycine, gentamicine, streptomycine, kanamycine).

Le traitement symptomatique de la mycoplasmose chez le chat comprend :
- Pour la conjonctivite : gouttes oculaires Gentaline, Divopride, Gentapharm, pommade à l’oxytétracycline.
- En cas d'atteinte du système génito-urinaire - antibiotiques inhibant le développement de la microflore pathogène (Lévomycétine, Amoxiclav), préparations à base de plantes (Stop-Cystite, KotErvin).
- Pour la polyarthrite, on utilise des anti-inflammatoires non stéroïdiens, des antihistaminiques et des analgésiques. Les immunomodulateurs (Amiksin, Nazoferon, Anaferon) et les vitamines B (thiamine, pyridoxine, cobalamine) font également partie du traitement de la mycoplasmose.
Prévention
Il n'existe actuellement aucun vaccin contre la mycoplasmose, mais un système immunitaire robuste peut réduire le risque d'infection, même chez un chat déjà infecté. Une alimentation équilibrée et des soins appropriés contribuent à renforcer ce système immunitaire. Les bactéries responsables de la mycoplasmose ne tolèrent ni la sécheresse ni la désinfection chimique. Il est donc recommandé de maintenir les chats dans des endroits secs, de leur donner à manger dans des gamelles propres et de veiller à la propreté de leur litière.
Essayez d'éloigner votre chat des autres animaux et vérifiez les antécédents médicaux de ses partenaires potentiels. N'oubliez pas de consulter régulièrement votre vétérinaire, de veiller à ce que votre animal soit à jour dans ses vaccins et de lui administrer des traitements antiparasitaires.

La mycoplasmose féline n'est pas transmissible à l'homme. Les chats sont infectés par les souches gatae et felis, tandis qu'une autre souche, Mycoplasma hominis, représente un risque pour l'homme. Il est toutefois recommandé d'éviter tout contact étroit avec un animal infecté et, après avoir nettoyé sa literie ou sa litière, de se laver les mains au savon ou d'utiliser un gel hydroalcoolique.
Lire aussi :
- Maladies du chat : Tableau des symptômes
- Mon chat boite d'une patte avant ou arrière : que dois-je faire ?
- Que faire si un chat ne mange rien ?
Ajouter un commentaire